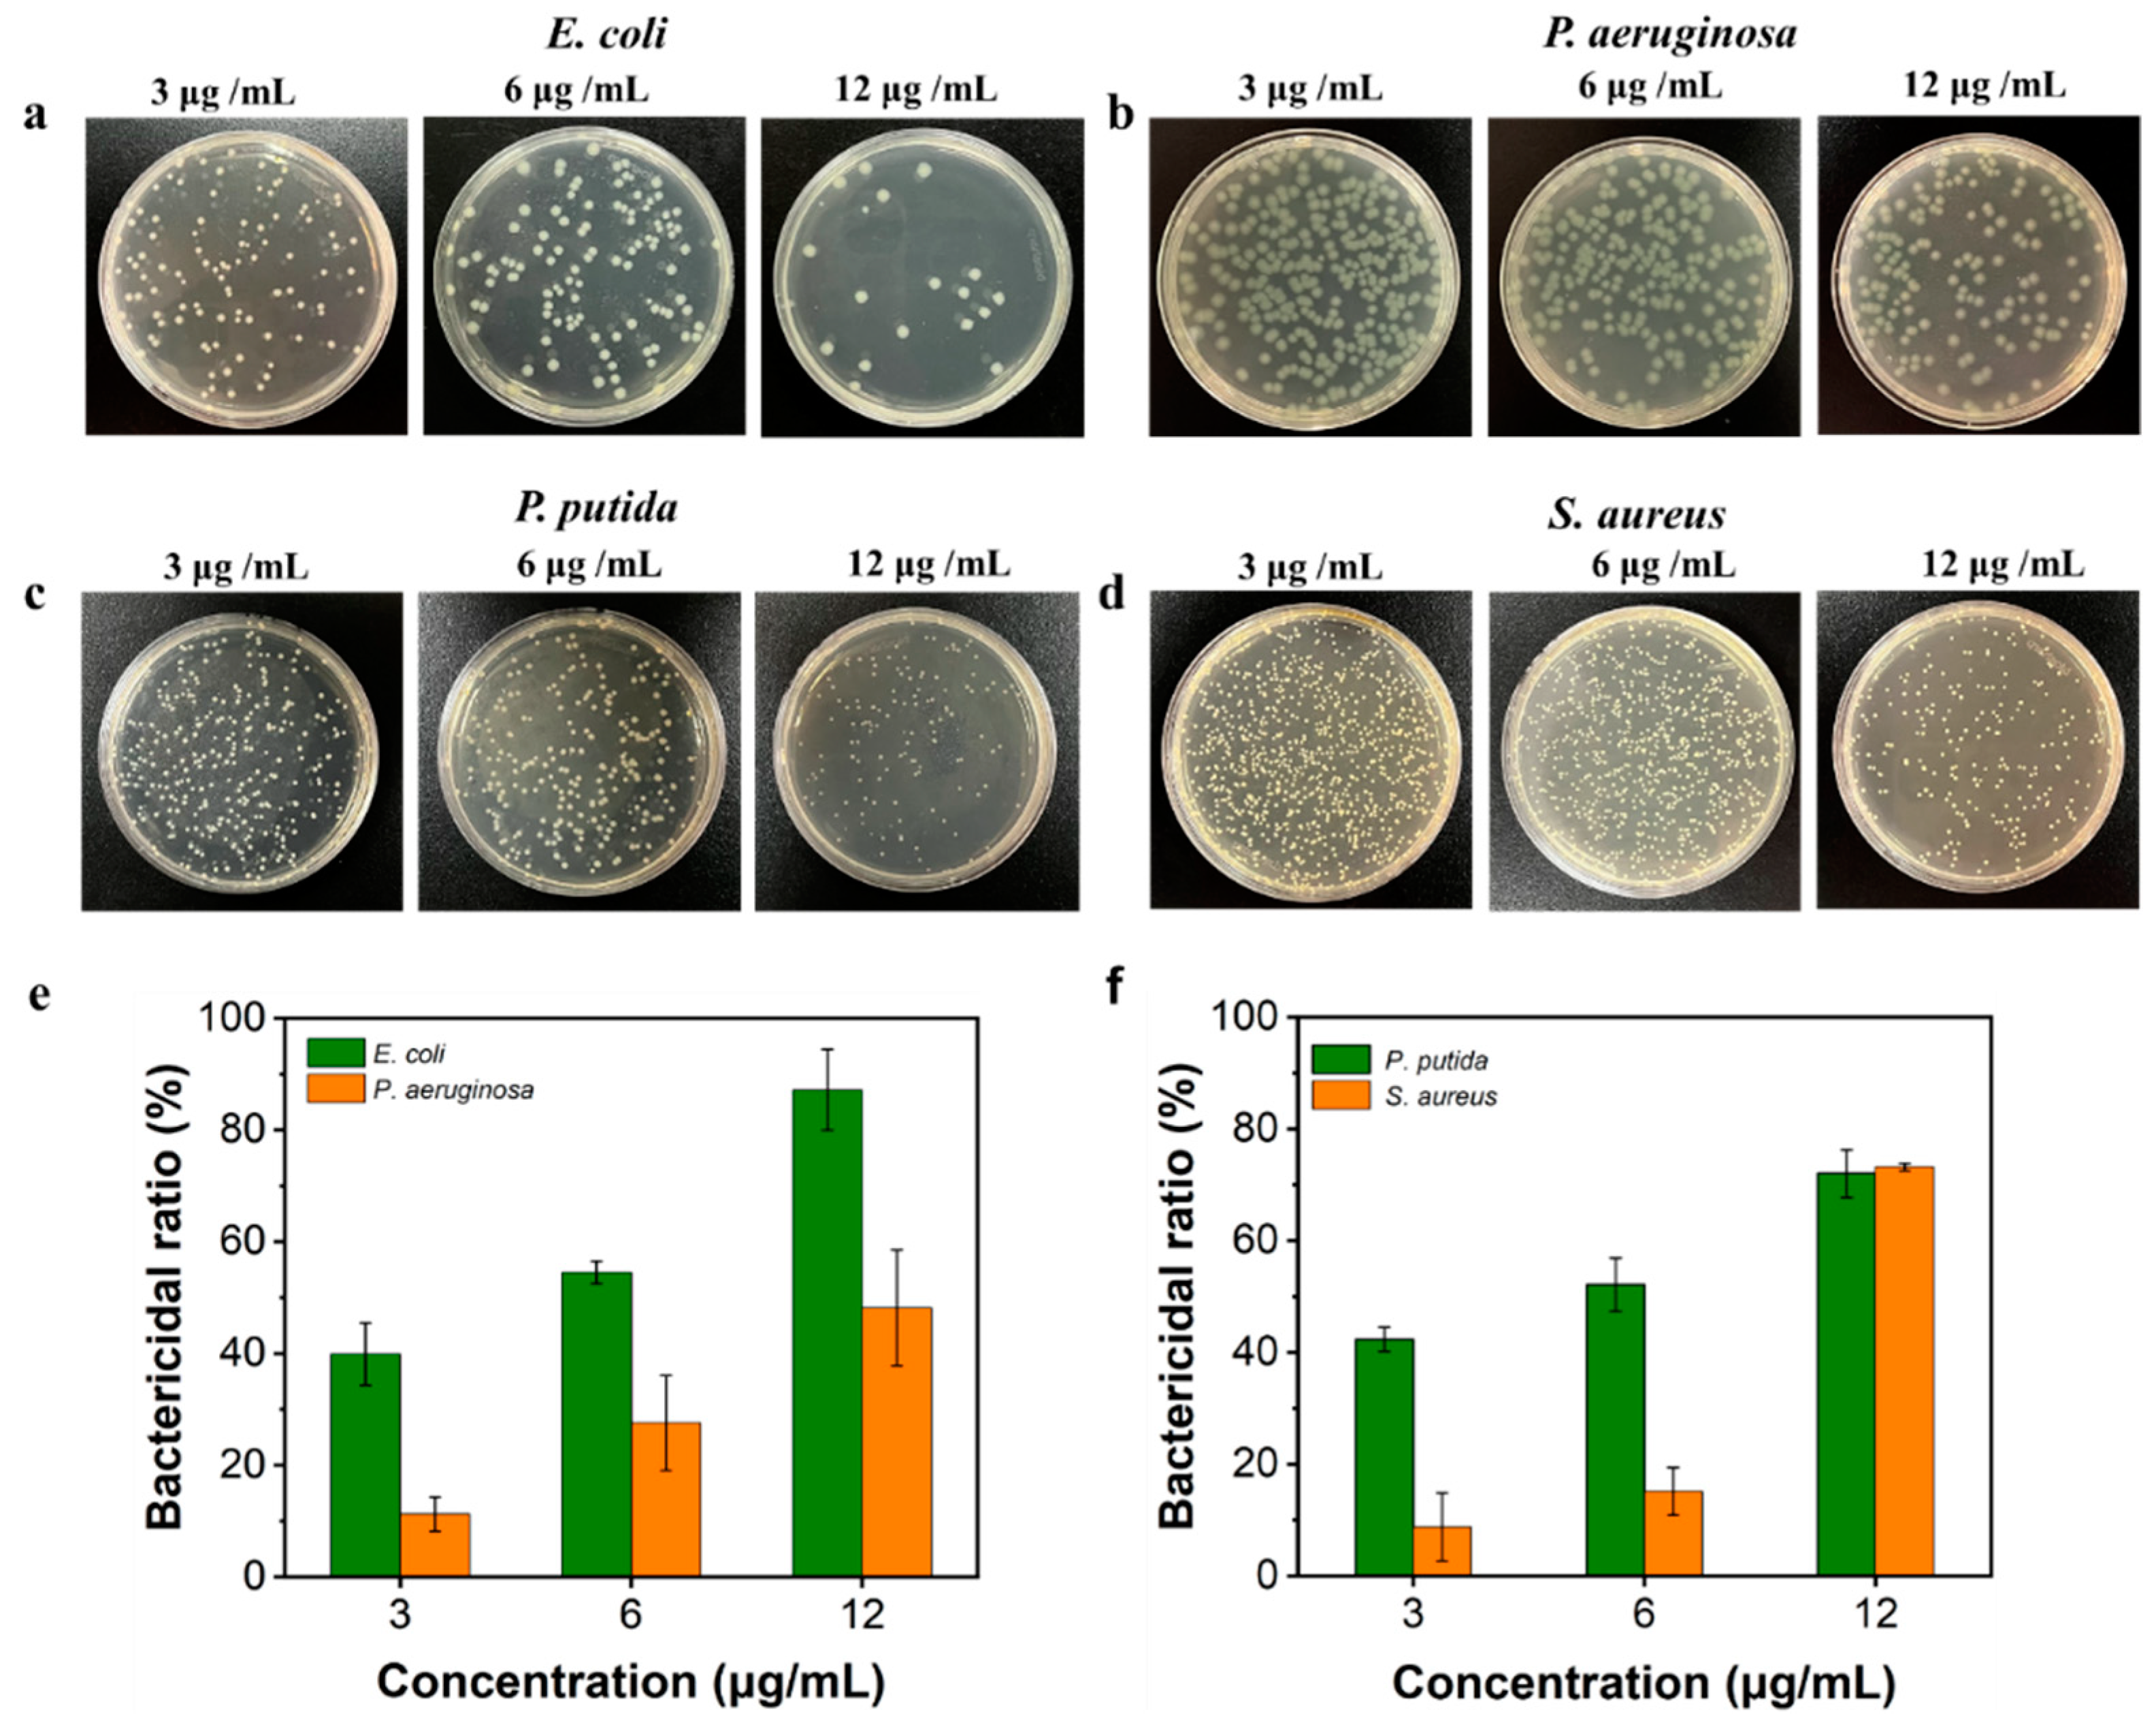
Nanomaterials 14 00957 g005

Solvent-Induced Lignin Conformation Changes Affect Synthesis and Antibacterial Performance of Silver Nanoparticle
Abstract
1. Introduction
2. Materials and Methods
2.1. Materials
2.2. One-Pot Synthesis of Silver Nanoparticles (AgNPs) Stabilized by Lignin (AgNPs@AL)
2.3. Characterization of AgNPs@AL
2.4. Dissolving Behavior of AgNPs@AL
2.5. Antibacterial Activity Test of AgNPs@AL Aqueous Dispersion
2.6. Interaction between AgNPs@AL and Bacteria Observed by TEM and SEM
2.7. In Vitro Cytotoxicity Assay of AgNPs@AL
3. Results and Discussion
3.1. Effect of Solvents Used for Dissolving Lignin on Properties of AgNPs@AL
3.2. Dissolving Behavior and Biocompatibility of AgNPs@AL
3.3. Evaluation of Bactericidal Potential of AgNPs@AL Aqueous Dispersion
3.4. Antibacterial Mechanism of AgNPs@AL
4. Conclusions
Supplementary Materials
Author Contributions
Funding
Data Availability Statement
Conflicts of Interest
References
- Caniça, M.; Manageiro, V.; Abriouel, H.; Moran-Gilad, J.; Franz, C.M.A.P. Antibiotic resistance in foodborne bacteria. Trends Food Sci. Technol. 2019, 84, 41–44. [Google Scholar] [CrossRef]
- Tacconelli, E.; Carrara, E.; Savoldi, A.; Harbarth, S.; Mendelson, M.; Monnet, D.L.; Pulcini, C.; Kahlmeter, G.; Kluytmans, J.; Carmeli, Y.; et al. Discovery, research, and development of new antibiotics: The WHO priority list of antibiotic-resistant bacteria and tuberculosis. Lancet Infect. Dis. 2018, 18, 318–327. [Google Scholar] [CrossRef] [PubMed]
- Yang, N.; Sun, M.; Wang, H.; Hu, D.; Zhang, A.; Khan, S.; Chen, Z.; Chen, D.; Xie, S. Progress of stimulus responsive nanosystems for targeting treatment of bacterial infectious diseases. Adv. Colloid Interface Sci. 2024, 324, 103078. [Google Scholar] [CrossRef]
- Li, P.-P.; Zhang, Y.; Wang, C.; Wang, S.-J.; Yan, W.-Q.; Xiao, D.-X.; Kang, J.; Yang, D.-Z.; Wu, H.-X.; Dong, A. Promotion of reactive oxygen species activated by nanosilver surface engineering for resistant bacteria-infected skin tissue therapy. Rare Met. 2023, 42, 4167–4183. [Google Scholar] [CrossRef]
- Shang, Z.; Chan, S.Y.; Song, Q.; Li, P.; Huang, W. The Strategies of Pathogen-Oriented Therapy on Circumventing Antimicrobial Resistance. Research 2020, 2020, 2016201. [Google Scholar] [CrossRef] [PubMed]
- Devi, N.; Saima; Pandey, S.K.; Kaur, D.; Kumar, V.; Sharma, R.K.; Wangoo, N. Membrane Penetrating-Cationic Peptide BP100 Functionalized Silver Nanoparticles as Efficient Antibacterial Agents. ACS Appl. Nano Mater. 2024, 7, 4731–4741. [Google Scholar] [CrossRef]
- Wang, Y.; Li, Z.; Yang, D.; Qiu, X.; Xie, Y.; Zhang, X. Microwave-mediated fabrication of silver nanoparticles incorporated lignin-based composites with enhanced antibacterial activity via electrostatic capture effect. J. Colloid Interface Sci. 2021, 583, 80–88. [Google Scholar] [CrossRef]
- Wang, L.; Wang, Q.; Slita, A.; Backman, O.; Gounani, Z.; Rosqvist, E.; Peltonen, J.; Willför, S.; Xu, C.; Rosenholm, J.M.; et al. Digital light processing (DLP) 3D-fabricated antimicrobial hydrogel with a sustainable resin of methacrylated woody polysaccharides and hybrid silver-lignin nanospheres. Green Chem. 2022, 24, 2129–2145. [Google Scholar] [CrossRef]
- Siddique, A.B.; Amr, D.; Abbas, A.; Zohra, L.; Irfan, M.I.; Alhoshani, A.; Ashraf, S.; Amin, H.M.A. Synthesis of hydroxyethylcellulose phthalate-modified silver nanoparticles and their multifunctional applications as an efficient antibacterial, photocatalytic and mercury-selective sensing agent. Int. J. Biol. Macromol. 2024, 256, 128009. [Google Scholar] [CrossRef]
- Behera, T.; Sarangi, B.; Mishra, D.; Pattnaik, S.; Parhi, P.; Behera, N. Salophen Anchored Silver Nanoparticle as Nanoprobe Designed for Selective Sensing and Antibacterial Activity. ChemistrySelect 2024, 9, e202303863. [Google Scholar] [CrossRef]
- Sharma, V.K.; Sayes, C.M.; Guo, B.; Pillai, S.; Parsons, J.G.; Wang, C.; Yan, B.; Ma, X. Interactions between silver nanoparticles and other metal nanoparticles under environmentally relevant conditions: A review. Sci. Total Environ. 2019, 653, 1042–1051. [Google Scholar] [CrossRef]
- Bellingeri, A.; Scattoni, M.; Venditti, I.; Battocchio, C.; Protano, G.; Corsi, I. Ecologically based methods for promoting safer nanosilver for environmental applications. J. Hazard. Mater. 2022, 438, 129523. [Google Scholar] [CrossRef] [PubMed]
- Li, K.; Zhong, W.; Li, P.; Ren, J.; Jiang, K.; Wu, W. Antibacterial mechanism of lignin and lignin-based antimicrobial materials in different fields. Int. J. Biol. Macromol. 2023, 252, 126281. [Google Scholar] [CrossRef]
- Lintinen, K.; Luiro, S.; Figueiredo, P.; Sakarinen, E.; Mousavi, Z.; Seitsonen, J.; Rivière, G.N.S.; Mattinen, U.; Niemelä, M.; Tammela, P.; et al. Antimicrobial Colloidal Silver–Lignin Particles via Ion and Solvent Exchange. ACS Sustain. Chem. Eng. 2019, 7, 15297–15303. [Google Scholar] [CrossRef]
- Richter, A.P.; Brown, J.S.; Bharti, B.; Wang, A.; Gangwal, S.; Houck, K.; Cohen Hubal, E.A.; Paunov, V.N.; Stoyanov, S.D.; Velev, O.D. An environmentally benign antimicrobial nanoparticle based on a silver-infused lignin core. Nat. Nanotechnol. 2015, 10, 817–823. [Google Scholar] [CrossRef] [PubMed]
- Gautam, M.; Park, D.H.; Park, S.J.; Nam, K.S.; Park, G.Y.; Hwang, J.; Yong, C.S.; Kim, J.O.; Byeon, J.H. Plug-In Safe-by-Design Nanoinorganic Antibacterials. ACS Nano 2019, 13, 12798–12809. [Google Scholar] [CrossRef]
- Jabbar, A.; Abbas, A.; Assad, N.; Naeem-ul-Hassan, M.; Alhazmi, H.A.; Najmi, A.; Zoghebi, K.; Al Bratty, M.; Hanbashi, A.; Amin, H.M.A. A highly selective Hg2+ colorimetric sensor and antimicrobial agent based on green synthesized silver nanoparticles using Equisetum diffusum extract. RSC Adv. 2023, 13, 28666–28675. [Google Scholar] [CrossRef]
- Das, A.K.; Mitra, K.; Conte, A.J.; Sarker, A.; Chowdhury, A.; Ragauskas, A.J. Lignin—A green material for antibacterial application—A review. Int. J. Biol. Macromol. 2024, 261, 129753. [Google Scholar] [CrossRef]
- You, S.-M.; Choi, J.-H.; Ryu, S.Y.; Byeon, J.W.; Kim, H.; Cha, H.G. Investigation of lignin substructures participating in self-assembly for the synthesis of monodisperse lignin spherical particles. Int. J. Biol. Macromol. 2024, 259, 129214. [Google Scholar] [CrossRef]
- Zheng, J.; Chen, L.; Huang, Z.; Qiu, X. Unraveling lignin extraction: Molecular dynamics insights into effective biomass valorization using a p-toluenesulfonic acid/solvents system. Green Chem. 2024, 26, 2783–2792. [Google Scholar] [CrossRef]
- Mukheja, Y.; Kaur, J.; Pathania, K.; Sah, S.P.; Salunke, D.B.; Sangamwar, A.T.; Pawar, S.V. Recent advances in pharmaceutical and biotechnological applications of lignin-based materials. Int. J. Biol. Macromol. 2023, 241, 124601. [Google Scholar] [CrossRef] [PubMed]
- Figueiredo, P.; Lintinen, K.; Hirvonen, J.T.; Kostiainen, M.A.; Santos, H.A. Properties and chemical modifications of lignin: Towards lignin-based nanomaterials for biomedical applications. Prog. Mater. Sci. 2018, 93, 233–269. [Google Scholar] [CrossRef]
- Wang, J.; Chen, W.; Yang, D.; Fang, Z.; Liu, W.; Xiang, T.; Qiu, X. Photonic Lignin with Tunable and Stimuli-Responsive Structural Color. ACS Nano 2022, 16, 20705–20713. [Google Scholar] [CrossRef]
- Zhang, Y.; Cheng, G. Lignin-containing hydrogels: Transforming a low-value byproduct to absorbents, wound dressings and strain sensors. Chem. Eng. J. 2023, 475, 146460. [Google Scholar] [CrossRef]
- Li, Y.; Yang, D.; Li, P.; Li, Z. Lignin as a multi-functional agent for the synthesis of Ag nanoparticles and its application in antibacterial coatings. J. Mater. Res. Technol. 2022, 17, 3211–3220. [Google Scholar] [CrossRef]
- Lee, S.J.; Begildayeva, T.; Yeon, S.; Naik, S.S.; Ryu, H.; Kim, T.H.; Choi, M.Y. Eco-friendly synthesis of lignin mediated silver nanoparticles as a selective sensor and their catalytic removal of aromatic toxic nitro compounds. Environ. Pollut. 2021, 269, 116174. [Google Scholar] [CrossRef] [PubMed]
- Zhang, Y.; Hao, J.; Zhao, H.; Zhang, W.; Shi, G.; He, Y.; Zhou, S.; Qiao, X.; Pang, X. Preparation of Lignosulfonate@AgNPs Colloidal Nanocrystal Clusters through In Situ Reduction, Confined Growth, and Self-Assembly. ACS Sustain. Chem. Eng. 2023, 11, 11130–11139. [Google Scholar] [CrossRef]
- Ran, F.; Li, C.; Hao, Z.; Zhang, X.; Dai, L.; Si, C.; Shen, Z.; Qiu, Z.; Wang, J. Combined bactericidal process of lignin and silver in a hybrid nanoparticle on E. coli. Adv. Compos. Hybrid Mater. 2022, 5, 1841–1851. [Google Scholar] [CrossRef] [PubMed]
- Saratale, R.G.; Saratale, G.D.; Ghodake, G.; Cho, S.-K.; Kadam, A.; Kumar, G.; Jeon, B.-H.; Pant, D.; Bhatnagar, A.; Shin, H.S. Wheat straw extracted lignin in silver nanoparticles synthesis: Expanding its prophecy towards antineoplastic potency and hydrogen peroxide sensing ability. Int. J. Biol. Macromol. 2019, 128, 391–400. [Google Scholar] [CrossRef]
- Chen, L.; Shi, Y.; Gao, B.; Zhao, Y.; Jiang, Y.; Zha, Z.; Xue, W.; Gong, L. Lignin Nanoparticles: Green Synthesis in a γ-Valerolactone/Water Binary Solvent and Application to Enhance Antimicrobial Activity of Essential Oils. ACS Sustain. Chem. Eng. 2020, 8, 714–722. [Google Scholar] [CrossRef]
- Pathania, K.; Sah, S.P.; Salunke, D.B.; Jain, M.; Yadav, A.K.; Yadav, V.G.; Pawar, S.V. Green synthesis of lignin-based nanoparticles as a bio-carrier for targeted delivery in cancer therapy. Int. J. Biol. Macromol. 2023, 229, 684–695. [Google Scholar] [CrossRef]
- Ma, Q.; Wang, L.; Zhai, H.; Ren, H. Lignin dissolution model in formic acid–acetic acid–water systems based on lignin chemical structure. Int. J. Biol. Macromol. 2021, 182, 51–58. [Google Scholar] [CrossRef]
- Xue, Y.; Qiu, X.; Liu, Z.; Li, Y. Facile and Efficient Synthesis of Silver Nanoparticles Based on Biorefinery Wood Lignin and Its Application as the Optical Sensor. ACS Sustain. Chem. Eng. 2018, 6, 7695–7703. [Google Scholar] [CrossRef]
- Ullah, S.; Khalid, R.; Rehman, M.F.; Irfan, M.I.; Abbas, A.; Alhoshani, A.; Anwar, F.; Amin, H.M.A. Biosynthesis of phyto-functionalized silver nanoparticles using olive fruit extract and evaluation of their antibacterial and antioxidant properties. Front. Chem. 2023, 11, 1202252. [Google Scholar] [CrossRef] [PubMed]
- Cui, H.; Jiang, W.; Wang, C.; Ji, X.; Liu, Y.; Yang, G.; Chen, J.; Lyu, G.; Ni, Y. Lignin nanofiller-reinforced composites hydrogels with long-lasting adhesiveness, toughness, excellent self-healing, conducting, ultraviolet-blocking and antibacterial properties. Compos. Part B Eng. 2021, 225, 109316. [Google Scholar] [CrossRef]
- Morsali, M.; Moreno, A.; Loukovitou, A.; Pylypchuk, I.; Sipponen, M.H. Stabilized Lignin Nanoparticles for Versatile Hybrid and Functional Nanomaterials. Biomacromolecules 2022, 23, 4597–4606. [Google Scholar] [CrossRef]
- Chen, L.; Luo, S.-M.; Huo, C.-M.; Shi, Y.-F.; Feng, J.; Zhu, J.-Y.; Xue, W.; Qiu, X. New insight into lignin aggregation guiding efficient synthesis and functionalization of a lignin nanosphere with excellent performance. Green Chem. 2022, 24, 285–294. [Google Scholar] [CrossRef]
- Steinmetz, L.; Geers, C.; Balog, S.; Bonmarin, M.; Rodriguez-Lorenzo, L.; Taladriz-Blanco, P.; Rothen-Rutishauser, B.; Petri-Fink, A. A comparative study of silver nanoparticle dissolution under physiological conditions. Nanoscale Adv. 2020, 2, 5760–5768. [Google Scholar] [CrossRef]
- Wong, C.Y.Y.; Choi, A.W.-T.; Lui, M.Y.; Fridrich, B.; Horváth, A.K.; Mika, L.T.; Horváth, I.T. Stability of gamma-valerolactone under neutral, acidic, and basic conditions. Struct. Chem. 2017, 28, 423–429. [Google Scholar] [CrossRef]
- Cameron, S.J.; Hosseinian, F.; Willmore, W.G. A Current Overview of the Biological and Cellular Effects of Nanosilver. Int. J. Mol. Sci. 2018, 19, 2030. [Google Scholar] [CrossRef]
- Qin, Z.; Zheng, Y.; Wang, Y.; Du, T.; Li, C.; Wang, X.; Jiang, H. Versatile roles of silver in Ag-based nanoalloys for antibacterial applications. Coord. Chem. Rev. 2021, 449, 214218. [Google Scholar] [CrossRef]
- Zheng, K.; Setyawati, M.I.; Leong, D.T.; Xie, J. Antimicrobial silver nanomaterials. Coord. Chem. Rev. 2018, 357, 1–17. [Google Scholar] [CrossRef]
- Jiang, W.; Zhang, Y.; Yang, D.; Qiu, X.; Li, Z. Ultrasonic-assisted synthesis of lignin-based ultrasmall silver nanoparticles for photothermal-mediated sterilization. Int. J. Biol. Macromol. 2024, 262, 129827. [Google Scholar] [CrossRef]
- Jadhav, K.; Deore, S.; Dhamecha, D.; Hr, R.; Jagwani, S.; Jalalpure, S.; Bohara, R. Phytosynthesis of Silver Nanoparticles: Characterization, Biocompatibility Studies, and Anticancer Activity. ACS Biomater. Sci. Eng. 2018, 4, 892–899. [Google Scholar] [CrossRef]
- Yuan, X.; Setyawati, M.I.; Leong, D.T.; Xie, J. Ultrasmall Ag+-rich nanoclusters as highly efficient nanoreservoirs for bacterial killing. Nano Res. 2014, 7, 301–307. [Google Scholar] [CrossRef]
- Lin, F.; Qi, Q.; Zhang, J.; Zhou, W.; Zhang, J.; Fu, P.; Zhang, X.; Qiao, X.; Liu, M.; Pang, X.; et al. From Unimolecular Template to Silver Nanocrystal Clusters: An Effective Strategy to Balance Antibacterial Activity and Cytotoxicity. ACS Appl. Mater. Interfaces 2021, 13, 39806–39818. [Google Scholar] [CrossRef]
- Wang, H.; Wei, L.; Wang, Z.; Chen, S. Preparation, characterization and long-term antibacterial activity of Ag–poly(dopamine)–TiO2 nanotube composites. RSC Adv. 2016, 6, 14097–14104. [Google Scholar] [CrossRef]
- Torres-Mendieta, R.; Nguyen, N.H.A.; Guadagnini, A.; Semerad, J.; Łukowiec, D.; Parma, P.; Yang, J.; Agnoli, S.; Sevcu, A.; Cajthaml, T.; et al. Growth suppression of bacteria by biofilm deterioration using silver nanoparticles with magnetic doping. Nanoscale 2022, 14, 18143–18156. [Google Scholar] [CrossRef]
- Pérez-Tanoira, R.; Fernández-Arias, M.; Potel, C.; Carballo-Fernández, R.; Pérez-Castro, S.; Boutinguiza, M.; Górgolas, M.; Lusquiños, F.; Pou, J. Silver Nanoparticles Produced by Laser Ablation and Re-Irradiation Are Effective Preventing Peri-Implantitis Multispecies Biofilm Formation. Int. J. Mol. Sci. 2022, 23, 12027. [Google Scholar] [CrossRef]
- Chen, J.; An, L.; Bae, J.H.; Heo, J.W.; Han, S.Y.; Kim, Y.S. Green and facile synthesis of aminated lignin-silver complex and its antibacterial activity. Ind. Crops Prod. 2021, 173, 114102. [Google Scholar] [CrossRef]
- Fu, X.; Rehman, U.; Wei, L.; Chen, Z.-S.; Abourehab, M.A.S.; Kesharwani, P.; Cheng, Z.-H. Silver-dendrimer nanocomposite as emerging therapeutics in anti-bacteria and beyond. Drug Resist. Updates 2023, 68, 100935. [Google Scholar] [CrossRef] [PubMed]
- Zhang, L.; Lu, H.; Chu, J.; Ma, J.; Fan, Y.; Wang, Z.; Ni, Y. Lignin-Directed Control of Silver Nanoparticles with Tunable Size in Porous Lignocellulose Hydrogels and Their Application in Catalytic Reduction. ACS Sustain. Chem. Eng. 2020, 8, 12655–12663. [Google Scholar] [CrossRef]
- Slavin, Y.N.; Ivanova, K.; Hoyo, J.; Perelshtein, I.; Owen, G.; Haegert, A.; Lin, Y.-Y.; LeBihan, S.; Gedanken, A.; Häfeli, U.O.; et al. Novel Lignin-Capped Silver Nanoparticles against Multidrug-Resistant Bacteria. ACS Appl. Mater. Interfaces 2021, 13, 22098–22109. [Google Scholar] [CrossRef]
- Tran, N.T.; Nguyen, T.T.T.; Ha, D.; Nguyen, T.H.; Nguyen, N.N.; Baek, K.; Nguyen, N.T.; Tran, C.K.; Tran TT, V.; Le, H.V.; et al. Highly Functional Materials Based on Nano-Lignin, Lignin, and Lignin/Silica Hybrid Capped Silver Nanoparticles with Antibacterial Activities. Biomacromolecules 2021, 22, 5327–5338. [Google Scholar] [CrossRef]

| Solvents | Diameter of AgNPs@AL (nm) | PDI | Diameter of AgNPs (nm) | Zeta Potential (mV) | AgNPs Content (wt.%) |
|---|---|---|---|---|---|
| DMF | 56.1 | 0.366 | 10.9 ± 2.6 | −47.2 | 19.6 |
| Methanol | 63.2 | 0.264 | 11.7 ± 3.2 | −38.3 | 15.2 |
| DMSO | 107.0 | 0.132 | 10.4 ± 2.7 | −46.9 | 16.6 |
| Ethanol | 73.4 | 0.225 | 10.1 ± 3.7 | −42.0 | 21.8 |
| Acetone | 100.7 | 0.198 | 13.5 ± 2.2 | −46.6 | 10.9 |
| THF | 83.7 | 0.421 | 10.4 ± 2.6 | −43.6 | 7.1 |
| GVL | 108.5 | 0.222 | 6.2 ± 2.8 | −36.5 | 5.1 |
Disclaimer/Publisher’s Note: The statements, opinions and data contained in all publications are solely those of the individual author(s) and contributor(s) and not of MDPI and/or the editor(s). MDPI and/or the editor(s) disclaim responsibility for any injury to people or property resulting from any ideas, methods, instructions or products referred to in the content. |
© 2024 by the authors. Licensee MDPI, Basel, Switzerland. This article is an open access article distributed under the terms and conditions of the Creative Commons Attribution (CC BY) license (https://creativecommons.org/licenses/by/4.0/).
Share and Cite
Li, D.; Chen, L. Solvent-Induced Lignin Conformation Changes Affect Synthesis and Antibacterial Performance of Silver Nanoparticle. Nanomaterials 2024, 14, 957. https://doi.org/10.3390/nano14110957
Li D, Chen L. Solvent-Induced Lignin Conformation Changes Affect Synthesis and Antibacterial Performance of Silver Nanoparticle. Nanomaterials. 2024; 14(11):957. https://doi.org/10.3390/nano14110957
Chicago/Turabian StyleLi, Dan, and Liheng Chen. 2024. "Solvent-Induced Lignin Conformation Changes Affect Synthesis and Antibacterial Performance of Silver Nanoparticle" Nanomaterials 14, no. 11: 957. https://doi.org/10.3390/nano14110957
APA StyleLi, D., & Chen, L. (2024). Solvent-Induced Lignin Conformation Changes Affect Synthesis and Antibacterial Performance of Silver Nanoparticle. Nanomaterials, 14(11), 957. https://doi.org/10.3390/nano14110957
